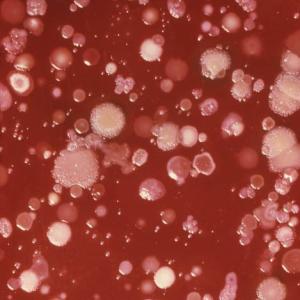
blood anthrax

Posted: May 23, 2013 | Author: bostonboomer | Filed under: Barack Obama, Crime, Foreign Affairs, morning reads, U.S. Politics | Tags: Boston Marathon bombings, Boston Police Department, Chechen community, Chechnya, closing Guantanamo, COINTELPRO, drones, Dzhokhar Tsarnaev, Emergency Planning and Community Right to Know Act, Emptywheel, FBI High Value Interrogation Group, homeland security, Ibragim Todashev, Kade Crockford, Massachusetts ACLU, National Defense University speech, National Response Center, Occupy Boston, Orlando FBI shooting, Reuters special report, spying on peace and environmental activists, Tamerlan Tsarnaev, Waltham MA triple murder, Watertown 2011 drug bust, West Tx fertilizer plant explosion |

Newsstand in Copley Square, Boston
Good Morning!!
I have lots of news updates for you today.
First, as I’m sure you heard, the Obama administration has finally admitted that it has killed four American citizens with drone strikes. Charlie Savage reported in The New York Times yesterday that President Obama will give a speech this afternoon at the National Defense University in which he will
open a new phase in the nation’s long struggle with terrorism on Thursday by restricting the use of unmanned drone strikes that have been at the heart of his national security strategy and shifting control of them away from the C.I.A. to the military….
As part of the shift in approach, the administration on Wednesday formally acknowledged for the first time that it had killed four American citizens in drone strikes outside the battlefields of Afghanistan and Iraq, arguing that its actions were justified by the danger to the United States. Mr. Obama approved providing new information to Congress and the public about the rules governing his attacks on Al Qaeda and its allies.
A new classified policy guidance signed by Mr. Obama will sharply curtail the instances when unmanned aircraft can be used to attack in places that are not overt war zones, countries like Pakistan, Yemen and Somalia. The rules will impose the same standard for strikes on foreign enemies now used only for American citizens deemed to be terrorists.
Lethal force will be used only against targets who pose “a continuing, imminent threat to Americans” and cannot feasibly be captured, Attorney General Eric H. Holder Jr. said in a letter to Congress, suggesting that threats to a partner like Afghanistan or Yemen alone would not be enough to justify being targeted.
Savage writes that Obama may eliminate drone attacks on groups of men assumed to be associated with al Qaeda that in the past have also killed many innocent civilians. He will also argue for closing the Guantanamo Bay prison and renewing efforts to return inmates to their “home countries.” CNN also has a helpful article on the President’s speech and proposed policy changes.
The speech will be at 2PM, and I will post a live blog if people are interested in watching it together. I’m sure it will be live streamed at C-Span and other news sites.
Important update on West, Texas disaster.
Yesterday evening Reuters released their own “Special Report.” on the situation.
(Reuters) – The fertilizer-plant explosion that killed 14 and injured about 200 others in Texas last month highlights the failings of a U.S. federal law intended to save lives during chemical accidents, a Reuters investigation has found.
Known as the Emergency Planning and Community Right to Know Act, the law requires companies to tell emergency responders about the hazardous chemicals stored on their properties. But even when companies do so, the law stops there: After the paperwork is filed, it is up to the companies and local firefighters, paramedics and police to plan and train for potential disasters.
West Fertilizer Co of West, Texas, had a spotty reporting record. Still, it had alerted a local emergency-planning committee in February 2012 that it stored potentially deadly chemicals at the plant. Firefighters and other emergency responders never acted upon that information to train for the kind of devastating explosion that happened 14 months later, according to interviews with surviving first responders, a failing that likely cost lives.
It’s a complex story, and you really should read the whole thing, because the West disaster is not an isolated incident.
The lack of preparedness endangers not only firefighters and emergency medical technicians, but also people nationwide living near chemical stockpiles similar to those that exploded in West.
At least 800,000 people in the United States live within a mile of 440 sites that store potentially explosive ammonium nitrate, which investigators say was the source of the explosion in West, according to a Reuters analysis of hazardous-chemical storage data maintained by 29 states.
Hundreds of schools, 20 hospitals, 13 churches and hundreds of thousands of homes in those states sit within a mile of facilities that store the compound, used in both fertilizers and explosives, the analysis found.
The rest of the states either refused to provide Reuters with data, provided “incomplete data” or simply didn’t respond to their requests.
Since 1990, companies have reported more than 380 incidents involving ammonium nitrate to the National Response Center, a federal agency that collects reports of spills, leaks and other discharges within the United States. Eight people were killed, 66 injured and more than 6,300 evacuated in those incidents, according to the center’s data.
But that doesn’t tell the whole story, because reporting of these kinds of incidents is voluntary!
Update on Boston Bombing Investigation
I spent most of yesterday following breaking updates in the Boston Marathon bombing case, which continues to get stranger by the day.
Early yesterday morning, there were reports of the FBI fatally shooting a man in Orlando, Florida with connections to accused (deceased) Boston bomber Tamerlan Tsarnaev. While the circumstance of the shooting are still not at all clear, here’s a brief summary of what I gleaned from reading hundreds of news reports.
Initially news reports said that a Chechen immigrant, Ibragim Todashev, had been shot by an unnamed FBI agent after Todashev attacked the agent with a knife during an interrogation at Todashev’s apartment house overnight. Todashev and a friend named Khusen Taramov had been interrogated for hours on Tuesday afternoon, according to Taramov. Then agents had let Taramov go while they continued questioning Todashev.
According to Taramov, he and his friend Todashev had been followed by law enforcement for some time and had been questioned previously. Todashev had been planning a trip home to Chechnya, but the FBI wanted wanted him to postpone it so they could continue to question him. The agents returned to question the two men further after midnight Wednesday when they learned that Todashev had decided to cancel his flight. That is when the shooting took place. At the time, two FBI agents from the Boston field office, two Massachusetts state troopers, and “other law enforcement” officers were present. It’s not clear who the other law enforcement officers were, but Emptywheel questioned yesterday whether they might have been from the FBI High Value Interrogation Group.
Later in the day it became clear that Todashev was considered a suspect in a shocking triple murder that took place in Waltham, MA two years ago on the tenth anniversary of 9/11. Todashev lived in the Boston area–in Allston, Cambridge, and Watertown; and was acquainted with Tamerlan Tsarnaev through their mutual involvement in MMA mixed martial arts fighting and the two had spoken by phone or Skype about a month before the marathon bombings. Todashev is not suspected of involvement in those.
As I reported here previously, Tamerlan and Dzhokhor Tsarnaev had reportedly been connected to the murders by “forensic” evidence, presumably DNA. One of the murdered men was Tamerlan’s “best friend,” Brian Mess. The three men had their throats slit and their bodies were covered with large amounts of marijuana and $5,000 in cash. After the murders, both Tsarnaev brothers stopped seeing friends and Tamerlan did not even attend Mess’s funeral. Not long after, Tamerlan traveled to Dagestan and stayed in Russia for nearly seven months.
Back to yesterday’s events. Later reports indicated that Todarov did not have a knife when he “lunged” at the FBI agent, and it was no longer clear which law enforcement officer or officers had shot the “suspect.” A team of FBI agents are in Orlando to review the shooting, and perhaps we’ll learn more about what actually happened.
Multiple news sources have reported that Todashev had implicated himself and Tamerlan Tsarnaev in the Waltham murders and that FBI agents were trying to get him to sign a written confession when he became enraged and attacked an agent, who sustained “non-life-threatening” injuries. Apparently Todashev didn’t want to sign whatever document the FBI agents had prepared for him. Since the FBI refuse to tape their interrogations, we may never know what the reported “implication” consisted of.
According to his friend Khusen Taramov, Todashev willingly answered the FBI’s questions.
The ex-roommate said Todashev shared the substance of his previous conversations with investigators with him and that he was completely forthcoming. That’s why he was surprised that Wednesday’s interview ended the way it did.
‘‘He told them everything,’’ Taramov said. ‘‘He told everything he knew. … I don’t know why that (the shooting) happened. It’s crazy.’’
But Taramov also said Todashev was afraid before Wednesday’s interview. ‘‘That’s what he asked me before he pretty much died,’’ Taramov said. ‘‘He asked me, ‘If something happens can you go out and tell all the truth, what exactly happened.’’’
It is clear that Todashev was prone to violence and people found him intimidating. He was involved in road rage incidents in Boston and Orlando.
Sorry I don’t have links for every detail, but the story is so complex and I’ve gotten information from so many sources that I thought it would be best for me to summarize it in my own words. There has been much more news breaking on this story, and I won’t try to include everything in this post. Anyone who is interested is welcome to ask me questions, and I’ll answer as best I can.
Here is one story from this morning from Fox Orlando: Moments leading to fatal FBI shooting in Orlando still unclear.
Federal and Central Florida law enforcement agencies are still collecting and processing evidence from the shooting scene at a condominium complex on Peregrine Avenue, near Kirkman Road and Universal Orlando, where Ibragim Todashev was shot early Wednesday.
Initially, FBI officials said Todashev, 27, became violent and lunged at an agent with a knife while he was being questioned about Tsarnaev and an unsolved 2011 triple murder in the Boston suburb of Waltham. The agent, acting on an “imminent threat,” then shot Todashev, they said.
Sources say Todashev, a Russian national living legally in Florida, was about to confess to the Waltham slaying when the shooting took place.
However, officials have backed off that preliminary account, and it’s no longer clear what happened in the moments before the fatal shooting.
“I heard a couple of loud bangs and saw a couple of cop cars riding by,” said Jared Morse, who lives in the area. “They wouldn’t let anyone out to see anything or anything like that, so they made us go back inside.”
There is one more possible connection between the Waltham murders and a massive drug bust that took place several months earlier in Watertown MA, in May 2011. It “followed a year-long investigation by federal authorities and resulted in charges against 18 people.” This was mentioned in a Washington Post Story yesterday that some friends of one of the murdered men believed there was a connection. As I’ve mentioned before, it’s likely the Tsarnaev brothers were financing their lifestyles with illegal activities, including drugs and possibly some kind of scam involving luxury cars.
Finally, a must-read article on the Boston saga and the failures of the Homeland Security Department and the Boston Police Department: BRIC-ED IN: WHY THE BPD DIDN’T THINK THAT TAMERLAN TSARNAEV WAS A KILLER. It’s a cautionary tale for anyone who lives in a large city that could be a terrorist target. Basically, the article describes how the BPD ignored terror warnings and instead spent millions on surveillance of Occupy Boston and other peace and environmental groups. COINTELPRO all over again. One representative of the Massachusetts ACLU had some suggestions.
According to Kade Crockford, who tracks the BRIC for the ACLU of Massachusetts, it’s about time that authorities reconsider their priorities. “A big question,” she says, “is whether efforts to build a bigger intelligence haystack may actually be less effective than improving traditional policing methods that focus on solving crimes …”
“Perhaps instead of extensively monitoring activists who are petitioning the government through the democratic process, law enforcement resources should focus on investigating and solving actual crimes, starting with murder.”
“Fewer resources tracking peace activists and more focus on traditional homicide detective work might be the best way to ensure a world in which we are both safe and free.”
I’ll end there, and open the floor to anything you want to discuss. Please post your links in the comments and have a great Thursday!
Did you like this post? Please share it with your friends:
Posted: May 24, 2012 | Author: bostonboomer | Filed under: Catfood Commission, Democratic Politics, morning reads, U.S. Economy, U.S. Military, U.S. Politics | Tags: Alan Simpson, austerity, Barack Obama, Bush tax cuts, CBO, Charles P. Pierce, CIA leak case, Corey Booker, education policy, Emptywheel, eurozone crisis, fiscal cliff, Iraq War, Joe Wilson, John Maynard Keynes, Mark Halperin, Massachusetts public schools, Mitt Romney, Patrick Fitzgerald, Scooter Libby, Social Security, unemployment, Valerie Plame |

Good Morning!! I’ve got a potpourri of interesting links for you today, so I’ll get right to it.
Yesterday Mitt Romney gave an interview to Mark {Gag!} Halperin of Time. Halperin asked the putative Republican nominee to say specifically what the unemployment rate would be after his first year as POTUS. You may recall that not long ago, Romney stated that unemployment should be below 4 percent and that anything higher than that is unacceptable. But now he’s singing a different tune.
Romney: I can’t possibly predict precisely what the unemployment rate will be at the end of one year. I can tell you that over a period of four years, by virtue of the policies that we’d put in place, we’d get the unemployment rate down to 6%, and perhaps a little lower. It depends in part upon the rate of growth of the globe, as well as what we’re seeing here in the United States, but we’d get the rate down quite substantially, and frankly, the key is we’re going to show such job growth that there will be competition for employees again. And wages – we’ll see the end of this decline we’re having. The median income in America is down 10% in just the last four years. That’s got to stop. We’ve got to start seeing rising wages and job growth.

Romney gave no specifics about how he would achieve this with the policies he has been promoting–cutting taxes on the rich, raising them on people with lower incomes, and cutting everything except defense spending, which he would increase substantially. Halperin did ask for more specifics, but Romney just babbled a bunch of nonsense:
Halperin: One more question generally about jobs. For people out there, for voters who want to know what you’re about in terms of job creation, is there some new idea, some original idea, that hasn’t been part of the debate in American politics before, that you have that you think would lead to a lot of new jobs?
Romney: Well the wonderful thing about the economy is that there’s not just one element that somehow makes the whole economy turn around, or everybody in the world would have figured that out and said there’s just one little thing we have to do – you know, Greece is settled, and France and Italy are all back and well again. No, it’s a whole series of things. It’s a system of factors that come together to make an economy work. What is it that makes America’s economy the strongest in the world, the most robust, over a century? It’s a whole series of things – everything from our financial service sector, to the cost of our inputs, our natural resources, to the productivity of our workforce, to our labor and management rules and how they work together, to our appreciation for fair trade and free trade around the world, and negotiating trade arrangements that are favorable to us. It is a whole passel of elements that come together to create a strong economy, and for someone who spent their life in the economy, they understand how that works. And it’s very clear, by virtue of the President’s record, that he does not, and he is struggling. Look at him right now. He just doesn’t have a clue what to do to get this economy going. I do. I laid out a 59-step plan that encompasses a whole series of efforts that will together get this economy going and put people back to work.
But from what I could make out in wading through all the blather, it really comes down to the confidence that will wash through all of us once we know that Mr. Fixit, Willard Mitt Romney is going to save us.
Romney: Well actually if I’m lucky enough to be elected the consumers and the small-business people in this country will realize that they have a friend in the White House, who is actively going to encourage economic growth, and there will be a resurgence in confidence in this country and a willingness to take risks, to invest, to add employees. I think it will be very positive news to the American economy. Will I be able to get done between January 1 and January 20 the things that I’d like to do? Of course not, I’m not in office. But I believe that we will be able to have a grace period, which allows us to tackle these issues one by one and put in place a structure, which is very much designed to get America working again.
Romney also gave a speech about education policy in which he proposed to further privatize America’s education system:
Mitt Romney proposed a series of steps to overhaul the public education system, reigniting the debate over school choice as his campaign intensifies its effort to introduce the presumptive Republican presidential nominee to a general-election audience.
The education plan, detailed in a speech today in Washington, would create a voucher-like system to give low- income and disabled students federal funds to attend charter schools, private institutions and public schools outside their district.
“I don’t like the direction of American education, and as president, I will do everything in my power to get education on track for the kids of this great land,” Romney told a gathering of Latino business owners at the U.S. Chamber of Commerce.
No new ideas there. To be perfectly honest, I strongly doubt that Romney knows the first thing about American public schools. But let me refer you to an expert on Willard’s past history in dealing with public education, the one and only Charles P. Pierce. Pierce writes about what Romney did to the public education system of Massachusetts during his one term as Governor:
Read the rest of this entry »
Did you like this post? Please share it with your friends:
Posted: February 18, 2012 | Author: bostonboomer | Filed under: Crime, Media, U.S. Politics | Tags: Amine El Khalifi, Detroit, Emptywheel, fake terrorists, FBI, FBI informants, Joseph Cannon, Kurt Haskell, Michael Chertoff, Mother Jones, naked body scanners, sting operations, TSA, Umar Farouk Abulmatallab, Underwear Bomber |

Amine El Khalifi, the latest victim of an FBI sting
Yesterday, the FBI arrested another fake terrorist, just one in a long line of potential “terrorists” who have been given training and equipment by the government and then busted as they try to carry out their “plots”–plots that seem to have been designed by–or at least strongly encouraged by–FBI agents. From The Washington Post:
Federal authorities on Friday arrested a 29-year-old Moroccan man in an alleged plot to carry out a suicide bombing at the U.S. Capitol, the latest in a series of terrorism-related arrests resulting from undercover sting operations.
For more than a year, Amine El Khalifi, of Alexandria, considered attacking targets including a synagogue, an Alexandria building with military offices and a Washington restaurant frequented by military officials, authorities said. When arrested a few blocks from the Capitol around lunchtime on Friday, he was carrying what he believed to be a loaded automatic weapon and a suicide vest ready for detonation.
The gun and vest were provided not by al-Qaeda, as Khalifi had been told, but by undercover FBI agents who rendered them inoperable, authorities said.
They said Khalifi had been the subject of a lengthy investigation and never posed a threat to the public….
Khalifi “allegedly believed he was working with al-Qaeda,” said Neil H. MacBride, U.S. attorney for the Eastern District of Virginia. Khalifi “devised the plot, the targets and the methods on his own.”
The Washington Post must think Americans are stupid. Emptywheel, who has done a great deal of research on these FBI sting operations, doesn’t seem to think Khalifi planned the “attack” by himself.
As is usual with most of FBI’s terrorist arrests of late, the FBI provided the suspect with the weapons he would have used to attack the target–in this case, the Capitol. As is usual, this appears to be an instance where the FBI found someone talking about violence–usually online–and then cultivated that violent desire over time.
So it seems like this is a now-familiar story.
Later in the post, she writes:
The FBI says his own plan was to be dropped off at the Capitol building.
But what happened instead is he did a Deep Throat in a parking garage to get his empty suicide vest.
So whose plan was he implementing, again?
I’m mentioning this arrest yesterday, because we’ve seen this repeated again and again. The FBI announces a big arrest and then later we learn that the whole plan was hatched by FBI agents who sucked in some angry kid and convinced him to commit some “terrorist act.”
On Thursday, just one day before the latest big FBI “terrorism” bust in DC, the so-called Underwear Bomber was sentenced to life in prison. ABC News (which also seems to think we’re stupid):

Umar Farouk Abulmatallab
Umar Farouk Abdulmutallab was the same remorseless man who four months ago pleaded guilty to all charges related to Northwest Airlines Flight 253. He seemed to relish the mandatory sentence and defended his actions as rooted in the Muslim holy book, the Quran.
“Mujahideen are proud to kill in the name of God,” he said. “Today is a day of victory.”
Had the bomb not fizzled, nearly 300 people aboard the flight would probably have been killed.
The case stirred renewed fears that terrorists could still bring down an American jetliner more than eight years after 9/11, and it accelerated installation of body scanners at the nation’s airports.
Please note that Abdulmutallab “was subdued by fellow passengers,” not anyone from law enforcement. Before the sentencing, four passengers and a member of the crew from Flight 253 were allowed to give victim impact statements. One of those statements came from Detroit attorney Kurt Haskell, whom the ABC “news” story characterizes as follows:
Because he was a passenger, Detroit-area lawyer Kurt Haskell was allowed to publicly repeat his wild claim that the U.S. government outfitted Abdulmutallab with a defective bomb partly to force the rollout of body-imaging machines at airports.

Kurt and Lori Haskell, who were on Flight 253
Is Haskell really making a “wild claim?” Here is his statement to the court:
I wish to thank the Court for allowing me these 5 minutes to make my statement. My references to the government in this statement refer to the Federal Government excluding this Court and the prosecution. On Christmas Day 2009, my wife and I were returning from an African safari and had a connecting flight through Amsterdam. As we waited for our flight, we sat on the floor next to the boarding gate. What I witnessed while sitting there and subsequent events have changed my life forever. While I sat there, I witnessed Umar dressed in jeans and a white t-shirt, being escorted around security by a man in a tan suit who spoke perfect American English and who aided Umar in boarding without a passport. The airline gate worker initially refused Umar boarding until the man in the tan suit intervened. The event meant nothing to me at the time. Little did I know that Umar would try to kill me a few hours later as our flight approached Detroit. The final 10 minutes of our flight after the attack were the worst minutes of my life. During those 10 minutes I sat paralyzed in fear. Unfortunately, what happened next has had an even greater impact on my life and has saddened me further.
When we landed, I was shocked that our plane taxied up to the gate. I was further shocked that we were forced to sit on the plane for 20 minutes with powder from the so called bomb all over the cabin. The officers that boarded the plane did nothing to ensure our safety and did not check for accomplices or other explosive devices. Several passengers trampled through parts of the bomb as they exited the plane. We were then taken into the terminal with our unchecked carry on bags. Again, there was no concern for our safety even though Umar told the officers that there was another bomb on board as he exited the plane. I wondered why nobody was concerned about our safety, accomplices or other bombs and the lack of concern worried me greatly. I immediately told the FBI my story in order to help catch the accomplice I had seen in Amsterdam. It soon became obvious that the FBI wasn’t interested in what I had to say, which upset me further. For one month the government refused to admit the existence of the man in the tan suit before changing course and admitting his existence in an ABC News article on January 22, 2010. That was the last time the government talked about this man. The video that would prove the truth of my account has never been released. I continue to be emotional upset that the video has not been released. The Dutch police, meanwhile, in this article (show article), also confirmed that Umar did not show his passport in Amsterdam which also meant that he didn’t go through security as both are in the same line in Amsterdam. It upsets me that the government refuses to admit this fact.
I became further saddened from this case, when Patrick Kennedy of the State Department during Congressional hearings, admitted that Umar was a known terrorist, was being followed, and the U.S. allowed him into the U.S. so that it could catch Umar’s accomplices. I was once again shocked and saddened when Michael Leiter of the National Counter terrorism Center admitted during these same hearings that intentionally letting terrorists into the U.S. was a frequent practice of the U.S. Government. I cannot fully explain my sadness, disappointment and fear when I realized that my government allowed an attack on me intentionally.
During this time, I questioned if my country intentionally put a known terrorist onto my flight with a live bomb. I had many sleepless nights over this issue. My answer came shortly thereafter. In late 2010, the FBI admitted to giving out intentionally defective bombs to the Portland Christmas Tree Bomber,the Wrigley Field Bomber and several others. Further, Mr. Chambers was quoted in the Free Press on January 11, 2011 when he indicated that the government’s own explosives experts had indicated that Umar’s bomb was impossibly defective. I wondered how that could be. Certainly, I thought, Al Qaeda wouldn’t go through all of the trouble to plan such an attack only to provide the terrorist with an impossibly defective bomb.
I attended nearly all of the pretrial hearings. At the hearing on January 28, 2011, I was greatly disappointed by the prosecution’s request to block evidence from Mr. Chambers “as it could then be able to be obtained by third parties, who could use it in a civil suit against the government”. It really bothered me that the government apparently was admitting to wrongdoing of some kind as it admitted that it was concerned it would be sued. It further upset me to know that the government was putting its own interests ahead of those of the passengers.
When I attended the jury selection hearings, I questioned why versions of the same two questions kept coming up, those being:
1. Do you think whether you’ll be able to tell whether something is actually a bomb? and
2. Do you realize that sometimes the media doesn’t always tell the truth?
I continued to be greatly saddened at this point as I felt the truth continued to be hidden.
When Umar listed me as his only witness, I was happy to testify, not on his behalf, but on behalf of the truth. I never expected to testify, as my eyewitness account would have been too damaging to the myth that the government and media are putting forward. A mere 5 days after I was announced as a witness, there was an inexplicable guilty plea which exasperated me as I no longer would be testifying.
In closing I will just say that regardless of how the media and government try to shape the public perception of this case, I am convinced that Umar was given an intentionally defective bomb by a U.S. Government agent and placed on our flight without showing a passport or going through security, to stage a false terrorist attack to be used to implement various government policies.
The effect this matter has had on my life has been astounding and due to this case, I will never trust the government in any matter, ever.
In regards to sentencing, nothing I’ve said excuses the fact that Umar tried to kill me. He has waived his valid claim to the entrapment defense. Umar, you are not a great Muslim martyr, you are merely a “Patsy”. I ask the court to impose the mandatory sentence.
Haskell’s wife Lori says that she was treated pretty badly by the judge in the case. No one really wanted her or her husband to tell about what they saw and experienced on Christmas Day 2009.
I imagine Joseph Cannon and/or Emptywheel will write about this case again soon. They are both much better at this kind of thing than I am, so I thought I would just lay the facts out for you as I see them. If you are interested in more information, you can read Cannon’s previous posts on the underwear bomber here and Emptywheel’s here.
What do you think? (Keeping in mind that former DHS head Michael Chertoff made big bucks from the naked body scanners now being used by the TSA.)
Did you like this post? Please share it with your friends:
Posted: December 15, 2011 | Author: bostonboomer | Filed under: #Occupy and We are the 99 percent!, 2012 presidential campaign, Banksters, Barack Obama, Civil Liberties, George W. Bush, income inequality, indefinite detention, Medicare, morning reads, net-neutrality, Psychopaths in charge, Republican presidential politics, U.S. Economy, U.S. Military, U.S. Politics, We are so F'd, WE TOLD THEM SO | Tags: ACLU, Afghanistan War, AUMF, Carl Levin, CEO salaries, defense authorization bill, Diane Feinstein, Emptywheel, Harry Truman, Human Rights Watch, indefinite detention, Iraq War, John McCain, Newt Gingrich, taxes, terrorism |

Good Morning!!
So far I haven’t been locked up in Guantanamo or debtors’ prison. I hope the rest of you Sky Dancers still have your freedom too, such as it is.
Yesterday the U.S. House of Representatives passed the Defense Authorization bill, which includes language permitting indefinite detention by the military of “al Qaeda members” without specific charges or trials. You can read the bill here.
Our craven and cowardly President had promised to veto this bill, but today the White House reneged on that promise, and Obama is set to sign it once it passes the Senate tomorrow or Friday.
The White House backed down from its veto threat of the defense authorization bill Wednesday, saying that the bill’s updated language would not constrain the Obama administration’s counterterrorism efforts.
While the White House acknowledged it still has some concerns, press secretary Jay Carney said President Obama’s advisers wouldn’t recommend a veto, a threat that had been hanging over the Pentagon policy bill for the past month.
Obama and his crew don’t care about the fifth amendment, habeas corpus and all that jazz–just that the president is the one who decides who is an “al Qaeda member” and therefore will be whisked away to indefinite detention. Wanna bet there are suddenly going to be a lot of “al Qaeda members” in the Occupy movement? From Anti-War.com:
As revealed in the Senate deliberations last week, the Obama administration itself requested the principal authors of the provision – John McCain and Carl Levin – to include language authorizing due-process-free military custody for American citizens. The initial threat of veto was apparently nothing more than political theater on the part of the White House.
According to The Hill, the following changes satisfied the White House concerns:
The bill deleted the word “requirement” from the section on the military detention of terror suspects, which was among the most contentious parts of the bill.
The national security waiver allowing the executive branch to move terror suspects from military to civilian courts was placed in the president’s hands rather than the Defense secretary’s, a change Levin said Obama had asked for.
The conference bill was based on the Senate language, which was not as harsh as the House bill when it came to trying terror suspects in civilian courts.
The administration called the provision in the bill that establishes the authority for military detentions unnecessary because the executive branch already was given this authority following Sept. 11.
Carney’s statement said if the administration finds parts of the law “negatively impact our counterterrorism professionals and undercut our commitment to the rule of law,” it expects the bill’s authors will correct those problems.
Oh well, then no worries… Except that lots of people who care about the Constitution aren’t so happy about it. Here’s a statement from Laura Murphy of the ACLU:
“The president should more carefully consider the consequences of allowing this bill to become law,” Laura W. Murphy, director of the ACLU Washington Legislative Office. “If President Obama signs this bill, it will damage both his legacy and American’s reputation for upholding the rule of law. The last time Congress passed indefinite detention legislation was during the McCarthy era and President Truman had the courage to veto that bill. We hope that the president will consider the long view of history before codifying indefinite detention without charge or trial.”
Unfortunately, Barack Obama is no Harry Truman.
Here’s a statement from Human Rights Watch:
“By signing this defense spending bill, President Obama will go down in history as the president who enshrined indefinite detention without trial in US law,” said Kenneth Roth, executive director of Human Rights Watch. “In the past, Obama has lauded the importance of being on the right side of history, but today he is definitely on the wrong side.”
The far-reaching detainee provisions would codify indefinite detention without trial into US law for the first time since the McCarthy era when Congress in 1950 overrode the veto of then-President Harry Truman and passed the Internal Security Act. The bill would also bar the transfer of detainees currently held at Guantanamo into the US for any reason, including for trial. In addition, it would extend restrictions, imposed last year, on the transfer of detainees from Guantanamo to home or third countries – even those cleared for release by the administration.
There are currently 171 detainees at Guantanamo, many of whom have been imprisoned for nearly 10 years. As one of his first acts in office, Obama signed an executive order for the closure of Guantanamo within one year. Instead of moving quickly to close the prison and end the use of the discredited military commissions, he supported modifications to the Military Commissions Act.
“It is a sad moment when a president who has prided himself on his knowledge of and belief in constitutional principles succumbs to the politics of the moment to sign a bill that poses so great a threat to basic constitutional rights,” Roth said.
The bill also requires the US military take custody of certain terrorism suspects even inside the United States, cases that previously have been handled by federal, state and local law enforcement authorities. During debate over the bill, several senior administration officials, including the secretary of defense, attorney general, director of national intelligence, director of the FBI, and director of the CIA, all raised objections that this provision interfered with the administration’s ability to effectively fight terrorism. In the last 10 years over 400 people have been prosecuted in US federal courts for terrorism related offenses. Meanwhile during that same period, only six cases have been prosecuted in the military commissions.
“President Obama cannot even justify this serious threat to basic rights on the basis of security,” Roth said. “The law replaces an effective system of civilian-court prosecutions with a system that has generated the kind of global outrage that would delight recruiters of terrorists.”
The bill also reauthorizes the AUMF that Bush used to get us into Iraq. Emptywheel has a lengthy post in which she wonders: Feinstein’s “Fix” on AUMF Language Actually Authorize Killing American Citizens? You probably should read the whole thing, but here’s the summation:
…by affirming all purportedly existing statutory authority, DiFi’s “fix” not only reaffirmed the AUMF covering a war Obama ended today, but also affirmed the Executive Branch’s authority to use deadly force when ostensibly trying to detain people it claimed present a “significant threat of death or serious physical injury.” It affirms language that allows “deadly force” in the name of attempted detention.
In any case, it’s one or the other (or both). Either the AUMF language became acceptable to Obama because it included American citizens in the Afghan AUMF and/or it became acceptable because it affirmed the Executive Branch’s authority to use deadly force in the guise of apprehending someone whom the Executive Branch says represents a “significant threat.”
My guess is the correct answer to this “either/or” question is “both.”
So DiFi’s fix, which had the support of many Senators trying to protect civil liberties, probably made the matter worse.
In its more general capitulation on the veto, the Administration stated that the existing bill protects the Administration’s authority to “incapacitate dangerous terrorists.” “Incapacitate dangerous terrorists,” “use of deadly force” with those who present a “significant threat of death or serious physical injury.” No matter how you describe Presidential authority to kill Americans with no due process, the status quo appears undiminished.
Finally Al Jazeera asks: Is the principle of indefinite detention without trial now an accepted and permanent part of American life? I wonder if Michelle Obama is still proud to be an American today?
There is some other news, of course. For one thing, it seems as if Rep. Ron Wyden of Oregon must have more energy I can imagine having. As of today he managed to get the decisions on rural post office closings postponed until next May; he joined with Rep. Paul Ryan (!) to propose a medicare overhaul; and he and Darrel Isa (!) have proposed an alternative to the entertainment industry bill that would effectively shut down social networking on the internet. Check out those links if you’re interested.
One of my favorite economists, Robert Reich, has an analysis of Newt’s Tax Plan, and Why His Polls Rise the More Outrageous He Becomes.
Newt’s plan increases the federal budget deficit by about $850 billion – in a single year!
….
Most of this explosion of debt in Newt’s plan occurs because he slashes taxes. But not just anyone’s taxes. The lion’s share of Newt’s tax cuts benefit the very, very rich.
That’s because he lowers their marginal income tax rate to 15 percent – down from the current 35 percent, which was Bush’s temporary tax cut; down from 39 percent under Bill Clinton; down from at least 70 percent in the first three decades after World War II. Newt also gets rid of taxes on unearned income – the kind of income that the super-rich thrive on – capital-gains, dividends, and interest.
Under Newt’s plan, each of the roughly 130,000 taxpayers in the top .1 percent – the richest one-tenth of one percent – reaps an average tax cut of $1.9 million per year. Add what they’d otherwise have to pay if the Bush tax cut expired on schedule, and each of them saves $2.3 million a year.
To put it another way, under Newt’s plan, the total tax bill of the top one-tenth of one percent drops from around 38 percent of their income to around 10 percent.
What about low-income households? They get an average tax cut of $63 per year.
Oh, I almost forgot: Newt also slashes corporate taxes.
Wow!
Dakinikat clued me in to this post at Naked Capitalism: “Let Them Eat Pink Slips” CEO Pay Shot Up in 2010, which links to this article in the Guardian.
Chief executive pay has roared back after two years of stagnation and decline. America’s top bosses enjoyed pay hikes of between 27 and 40% last year, according to the largest survey of US CEO pay. The dramatic bounceback comes as the latest government figures show wages for the majority of Americans are failing to keep up with inflation.
America’s highest paid executive took home more than $145.2m, and as stock prices recovered across the board, the median value of bosses’ profits on stock options rose 70% in 2010, from $950,400 to $1.3m. The news comes against the backdrop of an Occupy Wall Street movement that has focused Washington’s attention on the pay packages of America’s highest paid.
The Guardian’s exclusive first look at the CEO pay survey from corporate governance group GMI Ratings will further fuel debate about America’s widening income gap. The survey, the most extensive in the US, covered 2,647 companies, and offers a comprehensive assessment of all the data now available relating to 2010 pay.
And these oligarchs couldn’t care less if we like it or not. They own the White House and the Congress and we don’t.
I’ll end with a bizarre and very sad story out of Utah:
Thousands of migratory birds were killed or injured after apparently mistaking a Wal-Mart parking lot, football fields and other snow-covered areas of southern Utah for bodies of water and plummeting to the ground in what one state wildlife expert called the worst mass bird crash she’d ever seen.
Crews went to work cleaning up the dead birds and rescuing the injured survivors after the creatures crash-landed in the St. George area Monday night.
By midday Wednesday, volunteers had helped rescue more than 3,000 birds, releasing them into a nearby pond. There’s no count on how many died, although officials estimate it’s upwards of 1,500.
“They’re just everywhere,” said Teresa Griffin, wildlife program manager for the Utah Division of Wildlife Resource’s southern region. “It’s been nonstop. All our employees are driving around picking them up, and we’ve got so many people coming to our office and dropping them off.”
Those are my recommendations for today. What are you reading and blogging about?
Did you like this post? Please share it with your friends:
Posted: October 11, 2011 | Author: bostonboomer | Filed under: Crime, morning reads, U.S. Politics | Tags: Amerithrax investigation, anthrax attacks of 2001, anthrax spores, Bruce Ivins, Emptywheel, FBI, Frank Olson, Jim White, Kappa Kappa Gamma, McClatchy new bureau, MKULTRA, Steven Hatfill |
Anthrax spores surrounding a red blood cell
Good Morning!!
For today’s morning reads, I’m going to focus on an important story that has long fascinated me: the anthrax attacks of 2001 and the FBI’s investigation of the case, which they dubbed “Amerithrax.” Did the FBI fail to really follow through on the investigation because of incompetence? Or is the government hiding something?
I’m sure you recall that just a week after the September 11 attacks, envelopes containing anthrax spores were mailed to several media offices and to Democratic Senators Tom Daschle and Patrick Leahy. Five people died from anthrax poisoning and seventeen others were infected, but survived. The UCLA School of Public health provides a list of anthrax attacks outbreaks in the U.S., including those related to the 2001 anthrax letters.

Steven Hatfill
The Bush administration tried to suggest that Iraq was somehow behind the attacks, but that hypothesis fell through when the chemical signature of the anthrax from the envelopes was shown to have come from a U.S. lab. The FBI then focused on Dr. Steven Hatfill, bio-weapons expert and virologist. When the FBI named Hatfill as a “person of interest,” the media went into a feeding frenzy, completely destroying this man’s career and reputation. In the end the government had to pay him a $5.8 million settlement.
In 2005, after the case against Hatfill fell apart, the agency found a new scapegoat in Bruce Ivins, an emotionally troubled bio-defense scientist at Ft. Detrick in Maryland. Ft. Detrick is notorious for its connection with the MKULTRA project and the mysterious suicide of distinguished researcher Frank Olson, who had been (probably) unknowingly dosed with LSD a couple of days earlier. But I digress. From the LA Times:
By the mid-1970s, Bruce Ivins had earned his doctorate and was a promising researcher at the University of North Carolina. By outward appearances, he was a charming eccentric, odd but disarming. Inside, he still smoldered with resentment, and he saw a new outlet for it.
Several years earlier, a Cincinnati student had turned him down for a date. He had projected his anger onto the young woman’s sorority, Kappa Kappa Gamma. There was a Kappa house in Chapel Hill, N.C., and Ivins cased the building. One night when it was empty, he slipped in through a bathroom window and roamed the darkened floors with a penlight.
Upstairs, he found something that fascinated him: a glass-enclosed sheaf of documents, called a cipher, necessary for decoding the sorority’s secrets. The cipher would help him wage a personal war against Kappa Kappa Gamma into the sixth decade of his life.
This was the side of himself that Ivins kept carefully hidden. He devised sneaky ways to strike anonymously at people or institutions he imagined had offended him. He harbored murderous fantasies about women who did not reciprocate his overtures. He bought bomb-making ingredients and kept firearms, ammunition and body armor in his basement.
Yet Ivins managed to work his way into the heart of the American biodefense establishment, becoming a respected Army scientist and an authority on the laboratory use of anthrax.

In fact, Ivins obsession with Kappa Kappa Gamma was the main connection the FBI had between Ivins and the anthrax letters–they were mailed from a box in Princeton, New Jersey that wasn’t far from a business office rented by the sorority. Jim White at Emptywheel writes:
One former object of Ivins’ attentions, researcher Nancy Haigwood, is relied upon almost exclusively for making the leap from Ivins’ obsession with the sorority to his role in the anthrax attacks….Haigwood began to suspect Ivins in the attacks because of an email he sent to her and others in November, 2001 highlighting his work with the anthrax isolated from the attacks. In one a photo in the email, he is handling culture plates without gloves, a break of containment protocol for working with such dangerous material. Haigwood felt that by sending out this photo, Ivins was emphasizing his immunity to anthrax because he had been vaccinated.
Haigwood later suggested Ivins to the FBI as a suspect, and the agency used pretzel logic to build a connection between Ivins’ Kappa fixation and the mailbox used in the anthrax attacks. But White explains that
this shaky claim already has been thoroughly destroyed. In this post from August, 2008,
Marcy [Emptywheel] showed that Ivins’ work records–from data released by the FBI–indicate that it would not have been possible for him to make the round trip to Princeton and put the letters in the mailbox with them getting the appropriate postmark[.]
Ivins committed suicide in 2008 by taking an overdose of Tylenol–after years of being followed and spied upon by the FBI and named as “an extremely sensitive suspect in the 2001 anthrax attacks.” After Ivins’ death, the FBI quickly closed the case and blamed the attacks on this man who could no longer defend himself and argued that no one else had been involved.
Yesterday morning, The New York Times published an article on the findings of a group of scientists who analyzed the FBI’s investigation and found it wanting. The results of their work will be published in the Journal of Bioterrorism & Biodefense.
[T]hree scientists argue that distinctive chemicals found in the dried anthrax spores — including the unexpected presence of tin — point to a high degree of manufacturing skill, contrary to federal reassurances that the attack germs were unsophisticated….
F.B.I. documents reviewed by The New York Times show that bureau scientists focused on tin early in their eight-year investigation, calling it an “element of interest” and a potentially critical clue to the criminal case. They later dropped their lengthy inquiry, never mentioned tin publicly and never offered any detailed account of how they thought the powder had been made.
The new paper raises the prospect — for the first time in a serious scientific forum — that the Army biodefense expert identified by the F.B.I. as the perpetrator, Bruce E. Ivins, had help in obtaining his germ weapons or conceivably was innocent of the crime.
The Times goes on to try to discredit the scientific analysis, but I just don’t buy it. Here is their summary of what the study authors had to say.
The tin is surprising because it kills micro-organisms and is used in antibacterial products. The authors of the paper say its presence in the mailed anthrax suggests that the germs, after cultivation and drying, got a specialized silicon coating, with tin as a chemical catalyst. Such coatings, known in industry as microencapsulants, are common in the manufacture of drugs and other products.
“It indicates a very special processing, and expertise,” said Martin E. Hugh-Jones, lead author of the paper and a world authority on anthrax at Louisiana State University. The deadly germs sent through the mail to news organizations and two United States senators, he added, were “far more sophisticated than needed.”
In addition to Dr. Hugh-Jones, the authors of the new paper are Barbara Hatch Rosenberg, a biologist, and Stuart Jacobsen, a chemist; both have speculated publicly about the case and criticized the F.B.I. for years.
But these scientist are not the only people who have questioned the FBI’s investigation. McClatchy published an article in May on their analysis of the FBI lab reports:
Buried in FBI laboratory reports about the anthrax mail attacks that killed five people in 2001 is data suggesting that a chemical may have been added to try to heighten the powder’s potency, a move that some experts say exceeded the expertise of the presumed killer.
The lab data, contained in more than 9,000 pages of files that emerged a year after the Justice Department closed its inquiry and condemned the late Army microbiologist Bruce Ivins as the perpetrator, shows unusual levels of silicon and tin in anthrax powder from two of the five letters.
Those elements are found in compounds that could be used to weaponize the anthrax, enabling the lethal spores to float easily so they could be readily inhaled by the intended victims, scientists say.
The existence of the silicon-tin chemical signature offered investigators the possibility of tracing purchases of the more than 100 such chemical products available before the attacks, which might have produced hard evidence against Ivins or led the agency to the real culprit.
But the FBI lab reports released in late February give no hint that bureau agents tried to find the buyers of additives such as tin-catalyzed silicone polymers.
I guess it was just more convenient to blame “crazy Bruce” instead of continuing to pursue the evidence wherever it might lead.
In a book released last month, Jeanne Guilleman “a medical anthropologist, a Professor of Sociology at Boston College and a senior fellow in the Security Studies Program at Massachusetts Institute of Technology,”is also highly critical of the FBI investigation.
Tonight at 9PM Eastern, the season premiere of PBS’s Frontline will “take a hard look” at the FBI’s investigation of Amerithrax. I plan to watch, and I hope you will too.
I think it may be time for an independent investigation of this crime. The FBI has already had ten years to solve it, but they’ve mainly managed to destroy the lives and careers of two men and cause untold pain to their families and friends.
Now what are you reading and blogging about this morning?
Did you like this post? Please share it with your friends:
Recent Comments